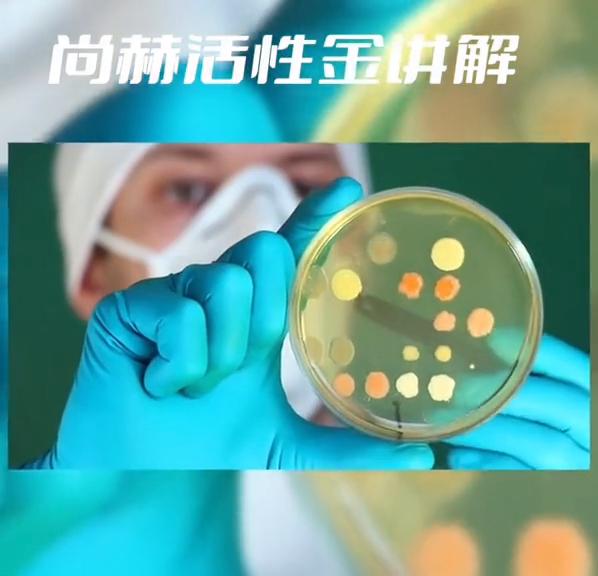
尚赫仪器多少钱一台正品,尚赫公司是合法的吗

尚赫活性金的介绍。黄金护肤是自古以来皇室贵族的美白秘方,埃及艳后带黄金面具睡觉,杨贵妃涂抹黄金面霜来护肤。慈禧太后不仅将黄金囚禁,还使用它来按摩脸部。据说巩俐也使用金属护肤品,这是许多女性信奉的美容秘方。黄金的传导力强,性质温和稳定,不会被皮肤排斥。金箔护肤品中的黄金经过纳米化处理后分子细小,容易被肌肤吸收,通过按摩促进血液循环,激发肌肤活力,增强肌肤弹性。配合按摩金箔护肤品,可以同时促进肌肤血液循环和活力,有助于恢复肌肤健康、润泽和金属箔的尊贵形象,是一种高级的美容享受。因此,女人一直对金箔护肤情有独钟。活性金护肤系列经过无数次配方筛选和严格的质量控制,采用国际先进技术和工艺制造而成。它采用独家先进美容技术,挑战美容市场新纪元,升级版添加了两大革命性成分,让肌肤穿越时空。活性金护肤系列包括四款产品:活性金洗面乳、活性金精华素、活性金眼霜、活性金保湿霜。使用步骤如下:活性金洗面乳、活性金果酸精华、透明质酸灵芝、木瓜山金车。护理功效:海藻淀粉、海藻蛋白枣红素,可调节酸碱平衡,消除肌肤过剩油脂,为肌肤提供营养,使肌肤滑爽。灵芝多糖具有独特的滋养和促进免疫机能的护理功效,可使皮肤自然润泽,抵御外界伤害和细菌污染,并保持肌肤弱碱性。活性精可促进营养物质的充分吸收。洁面后,使用活性金精华素,透明质酸海藻提取液、筋脉液、胶原蛋白、柠檬精油、马尾草提取液。成分:活性精、透明质酸、海藻提取液、筋脉液、胶原蛋白、维生素C、芦荟提取液、怕保湿因子、霍霍巴油。使用方法:早晚间使用温水将全脸打湿。取适量活性金洗面乳于手掌中,搓出泡沫后涂抹于脸部并轻轻按摩。再用温水洗净。活性金精华素、活性成分:活性精、透明质酸海藻提取液、筋脉液、胶原蛋白、薰衣草精油、马尾草提取液。护理功效:天然调节皮肤酸碱平衡和油脂分泌。性质温和,不含油脂,可迅速被皮肤吸收,不会堵塞毛孔。丰富的胶原蛋白和天然植物提取液为肌肤提供充足的水分和营养。天然马尾草萃取液配以活性金的导体作用,可使皮肤细致通透。促进前面毛细血管血液循环,达到明亮肌肤的功效。软化角质层,增加皮肤弹性,主要成分:年金海藻糖、水解胶原五肽一透明质酸钠。使用方法:洁面后,将适量产品均匀涂抹在面部和颈部皮肤,轻轻按摩至皮肤完全吸收。活性精保湿霜、活性成分:活性精、透明质酸柑橘提取液、怕保湿因子、芦荟提取液、维生素C、胶原蛋白、霍霍巴油。该产品含有柑橘提取液,能够清凉肌肤,促进散热解毒。同时,芦荟植物胶原纤维还能促进皮肤重建天然脂质膜,提高补水锁水能力,达到自然保湿的效果。该产品通过还原反应清除氧自由基,为深层细胞提供营养,有效延缓衰老,对抗松弛,使肌肤恢复年轻状态。该产品的天然防晒成分可以有效防止紫外线对皮肤的损伤,保护肌肤健康。该产品的主要成分包括活性金视黄醇、抗坏血酸磷酸酯钠、生育酚乙酸酯、五肽易水解胶原酵母提取物、人参根提取物、透明质酸钠和烟酰胺。使用方法:每天早晚使用精华素后,取适量均匀涂于面部,轻轻按摩至完全吸收。该产品还包括活性金眼霜,其主要成分包括活性金果酸精华、透明质酸金缕梅提取液、酵母精华、海藻多糖、维生素pp人参提取液,能够舒缓滋养眼部娇嫩肌肤,修护老化表皮细胞,促进细胞更新,防止细小皱纹产生,改善眼部周围血液循环,从而避免黑眼圈的出现,改善代谢消炎并消除浮肿。该产品的主要成分包括活性金视黄醇、抗坏血酸、磷酸酯钠、生育分乙酸酯、五肽一、透明质酸钠和水解胶原。使用方法:每天早晚使用精华素后,取适量均匀涂于面部肌肤上,轻轻按摩至完全吸收。